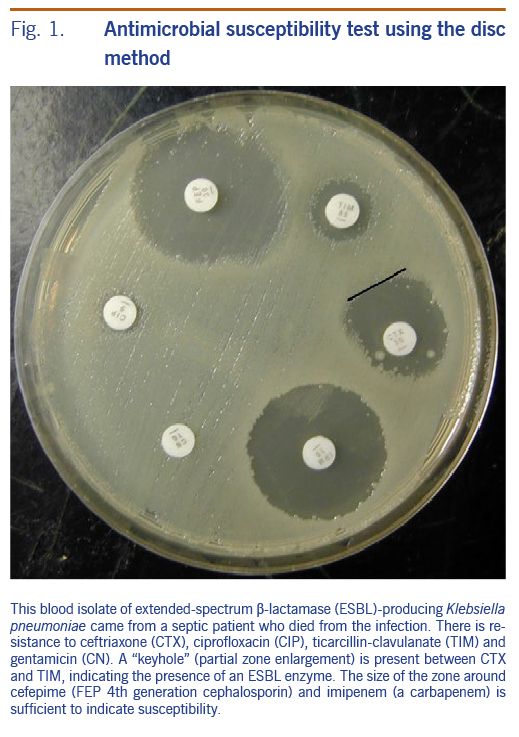

ANTIBIOGRAM PMGH 2018 final
Cumulative antibiograms summarise the collective susceptibility of bacterial isolates against various antibiotics. Prepared by Drs Jacklyn Joseph and John Ferguson, August 2019. Isolates were cultured from PMGH inpatients and outpatients served by the PMGH Laboratory. Outpatients came from clinic locations from around the National Capital District.
There is selection bias inherent in the samples included in hospital antibiograms and great care must be taken with its interpretation. Treatment guideline review and modification in the light of this antibiogram needs to take into account specific clinical data that assesses the response to treatment of both culture positive and negative infections across the different patient groups (paediatric, adult) and locations (intensive care, non intensive care, outpatient). Susceptibility rates at other institutions may differ significantly.
Where possible isolates derived from inadequate specimen types such as urinary catheter or endotracheal tube tips, have been excluded from analysis. However it is probable that many urine cultures may not have been collected for the correct reason or in the correct manner leading to the possibility of error due to contamination or sampling of patients with asymptomatic bacteriuria.